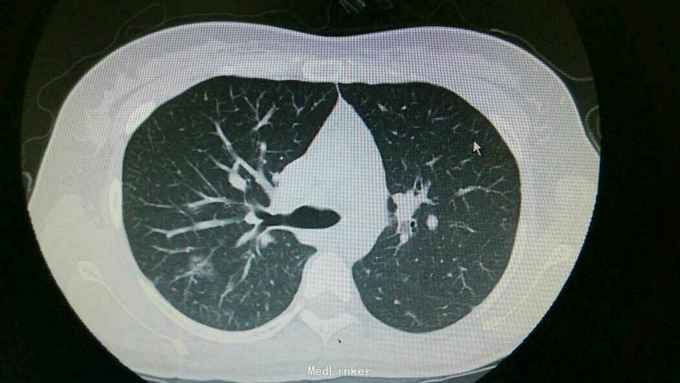

下载或打开 医联APP 查看完整评论
立即下载
打开APP
支原体肺炎
主诉 病史
主诉:咽痛,咳嗽1周余。 病史:患者1周前出现咽痛,咳嗽,伴有咳痰,为黄色粘稠痰,当时有发热,最高体温37.6摄氏度,伴有畏寒,寒战,余无不适就诊。
查体 辅查
查体:双肺呼吸音粗,右肺可闻及湿罗音, 余无特殊 辅查:血常规示中性粒细胞稍高。胸片:右上肺野炎性病变。肺炎支原体抗体滴度1:640。胸部CT:双肺炎症。

诊断 处理
诊断:支原体肺炎。 治疗,予以阿奇霉素抗感染,止咳化痰等处理。复查胸片提示炎症较前好转。

随访 讨论
讨论+随访:临床支原体肺炎为不典型肺炎,其诊断主要依靠支原体抗体滴度及影像学检查。一般治疗一个星期可好转。
发布于 15-12-26 19:41
